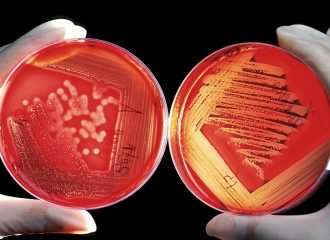

Najnowsze wpisy
-
#KupujŚwiadomie
na grilla – PRODUKT POLSKI5 years ago by zywnosc - Dieta w leczeniu wirusowego zapalenia wątroby5 years ago by zywnosc
-
Spółki Skarbu Państwa
rozważają inwestycje
w biogazownie rolnicze5 years ago by zywnosc -
Będzie wsparcie z PROW
za straty w związku
z COVID-195 years ago by zywnosc -
GK GPW rozszerza
ofertę produktową
na giełdowym rynku rolnym5 years ago by zywnosc